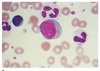

Which of the following genetic abnormalities is associated with acute promyelocytic leukemia?
a. T15;17
b. Inv 16
c. 16:16
d. 8:23
A. T15:17
Subtypes of AML are recognized due to the presence or absence of specific, recurrent cytogenetic, and/or genetic abnormalities. For example, the diagnosis of acute promyelocytic leukemia (APL) is based on the presence of either the t(15;17)(q22;q12) cytogenetic rearrangement or the PML-RARA fusion product of the translocation.
A 67 year old male with known chronic myeloid leukemia presents to the emergency room for sudden onset severe abdominal pain radiating to the back. His lab workup shows 3x elevated lipase and amylase. Which tyrosine kinase inhibitor is the likely cause of his symptoms?
a. Dasatinib
b. Imatinib
c. Bosutinib
d. Nilotinib
Ans. D. Nilotinib
Which infectious agent is associated with the development of lymphoplasmocytic lymphoma?
a. Epstein Barr Virus
b. Cytomegalovirus
c. Hepatitis B virus
d. Hepatitis C virus
Ans. D. Hepatitis C Virus
Most common chemotherapeutic regimen for Hodgkin’s Lymphoma
a. ABVD
b. R-CHOP
c. ICE
d. GND
Ans. A. ABVD
The most common chemotherapy regimen used to treat HL in the United States is ABVD (doxorubicin, bleomycin, vinblastine, and dacarbazine). This regimen is given every other week, with each cycle including two treatments. In patients with low-risk, or favorable, disease, the use of four to six cycles of ABVD alone, without radiation therapy, results in progression-free and overall survival rates of 88-92% and 97-100%, respectively, at 5-7 years.
R-CHOP (Rituximab, Cyclophosphamide, Vincristine and Prednisone) is first line for non-hodgkin’s lymphoma. ICE (Ifosfamide, Carboplatin and Etoposide) and GND (Gemcitabine, Vinorelbine, Doxorubicin) are used as a salvage chemotherapy.
A 64-year-old man is being evaluated for possible plasma cell dyscrasia. A bone marrow biopsy shows 20% clonal plasma cells. Which of the following additional findings fulfills a myeloma-defining event?
a. Serum calcium of 10.8 mg/dL (upper limit of normal 10.5 mg/dL)
b. Serum creatinine of 1.6 mg/dL with eGFR 55 mL/min
c. Hemoglobin of 11.2 g/dL (baseline 13.0 g/dL)
d. Spine MRI shows multiple 6–7 mm focal areas of abnormal marrow signal intensity
Ans. D. Spine MRI shows multiple 6–7 mm focal areas of abnormal marrow signal intensity
Symptomatic Multiple Myeloma
Clonal bone marrow plasma cells or biopsy-proven bony or extramedullary plasmacytomaª and any one or more of the following myeloma-defining events:
• Evidence of one or more indicators of end-organ damage that can be attributed to the underlying plasma cell proliferative disorder, specifically:
- Hypercalcemia: serum calcium >0.25 mmol/L (>1 mg/dL) higher than the upper limit of normal or >2.75 mmol/L (>11 mg/dL)
- Renal insufficiency: creatinine clearance <40 mL/min* or serum creatinine > 177 umol/L (>2 mg/dL)
- Anemia: hemoglobin value of >20 g/L below the lower limit of normal, or a hemoglobin value <100 g/L
- Bone lesions: one or more osteolytic lesions on skeletal radiography, CT, or PET-CT°
- Any one or more of the following biomarkers of malignancy:
- Clonal bone marrow plasma cell percentage* ≥60%
- Involved: uninvolved serum free light chain ratio” ≥100
- > 1 focal lesion on MRI studies
56-year-old man in the ICU for septic shock from pneumonia begins to have oozing at venipuncture sites and bleeding around his central line. His laboratory results show a platelet count of 68 × 10⁹/L, a markedly elevated D-dimer, a prothrombin time prolonged by 4.5 seconds, and a fibrinogen level of 0.8 g/L. Using the ISTH scoring system for overt DIC, what is this patient’s total score?
a. 3
b. 4
c. 6
d. 7
Ans. C. 6
ISTH Criteria for Overt DIC. For the patient: Platelet Count - 1, Elevated D-dimer - 3, Prolonged PT - 1, Fibrinogen <1 - 6.
A 29-year-old woman is brought to the emergency department 36 hours after an intentional ingestion of a large amount of paracetamol. She is confused, jaundiced, and has rapidly worsening encephalopathy. Her labs show: AST 6,800 U/L, ALT 7,500 U/L, INR 6.2, total bilirubin 9 mg/dL, platelets 210 × 10⁹/L, and fibrinogen 230 mg/dL.
The ICU team plans to place a central venous catheter and is concerned about her elevated INR. She is hemodynamically stable, not actively bleeding, and has no signs of DIC. Vitamin K has already been administered without improvement.
Which of the following is the most appropriate transfusion strategy to rapidly correct her coagulopathy prior to the procedure?
a. Fresh frozen plasma (FFP)
b. Cryoprecipitate
c. Four-factor prothrombin complex concentrate (4F-PCC)
d. Platelet transfusion
Ans. C. Four-factor prothrombin complex concentrate (4F-PCC)
Although treatment of bleeding with FFP was the standard approach to correcting hemostasis in patients with liver failure, the use of 4F-PCC is now favored due to lower volume, less increase in portal pressure, reduced risk of circulatory over- load, and other complications associated with FFP transfusion.
A 32 year old female with known systemic lupus erythematosus comes in for heavy menstrual losses was advised blood transfusion.
On latest lab tests her hemoglobin was 5.5 g/L.
She had a transfusion reaction during the last admission, manifesting as itching, hives, swollen lips and difficulty breathing and transfusion was stopped. The hematology service requests for an IgA level, which turned out to be low.
Which of the following blood products is the best for this patient?
a. Washed RBC
b. Packed RBC
c. Irradiated PRBC
d. Whole Blood
Ans. A. Washed PRBC
Patients who are IgA deficient (<1% of the population) may be sensitized to this immunoglobulin isotype and may be at risk of anaphylactic reactions associated with plasma transfusion. As a precaution, individuals with severe IgA deficiency should therefore receive, where available, IgA-deficient plasma and washed cellular BCs. Patients who have anaphylactic or repeated allergic reactions to BCs should be tested for IgA deficiency. It should be noted that the importance, or even the reality, of such a transfusion-related allergic risk is currently debated.
Which among the following is a cytokine that regulates macrophage and NK-cell activation?
a. IFN-alpha
b. IL-6
c. IFN-gamma
d. TNF-alpha
IFN-gamma attaches to the Type II interferon receptor of T-cells and NK cells to regulate macrophage and NK cell activation. They also induce class II histocompatibility antigens and Th1 T cell differentiation (vs another regulatory cytokine 1L-10, which inhibits differentiation of Th1 helper T cells)
IFN-alpha promotes antiviral activity and stimulates T-cell macrophages. It also has direct antitumor effects and are used therapeutically in viral and autoimmune conditions
TNF-alpha can cause fever, shock, anorexia through enhanced leukocyte cytotoxicity, enhanced NK-cell function, and proinflammatory cytokine induction
For patients with systemic mastocytosis, which of the following supportive therapies can be offered to alleviate malabsorption?
a. Aspirin
b. Dexamethasone
c. Oral cromolyn sodium
d. Ranitidine
Ans. B. Dexamethasone
The management of SM is symptom control using a stepwise symptom/sign–directed approach. Medications include an H 1 antihistamine for flushing and pruritus, an H 2 antihistamine or proton pump inhibitor for gastric acid hypersecretion, oral cromolyn sodium for diarrhea and abdominal pain, and occasionally aspirin (in those who are known to be tolerant of NSAIDs) for severe flushing to block biosynthesis of prostaglandin D2.
A 20 year old female with known Systemic lupus erythematosus had one abortion at 12 weeks age of gestation with morphologically normal fetus, and high titers of lupus anticoagulant repeated on 2 occasions 12 weeks apart. On review, the patient has already had previous deep vein thrombosis during her previous admission. She is not able to tolerate aspirin due to an allergic reaction. What is an appropriate approach to anticoagulation for this patient?
a. Warfarin alone, to target INR 2.0-3.0
b. Warfarin alone, to target INR 2.5-3.5
c. Warfarin alone, to target INR 3.0-4.0
d. Offer a DOAC, since the previous event was venous thrombosis
Ans. C. Warfarin alone, to target INR 3.0-4.0
Following the first thrombotic event, APS patients should be placed on vitamin K antagonists (VKAs) for life, aiming to achieve an international normalized ratio (INR) ranging from 2.0 to 3.0 in case of an unprovoked venous thrombosis. For patients with arterial thrombosis, the corresponding INR target should be 3.0–4.0 or 2.0–3.0 along with low-dose aspirin (LDA, 75–100 mg daily), depending on the thrombotic/hemorrhagic patient profile.
Normal range of hemoglobin
Males
Females
Males: 135–174 g/L
(Anemia <130g/l)
(Polycythemia: >170 or hct >60)
Female: 120-150 g/L
(Anemia <120 g/l)
(Polycythemia >150 or hct >55)
In a person whose reticulocyte count is 9%, hemoglobin 7.5 g/dL, hematocrit 23%, and MCV 75, what is the physiologic classification of anemia?
a. Hemolysis
b. Infiltration/fibrosis
c. Thalassemia
d. Drug toxicity
C. Thalassemia
RPI= retic count x (hgb/correctopn factor) / maturation time
= 9 x (7.5/15) / 2
= 2.25
RPI < 2.5 with microcytosis

Stages of Iron deficiency
A) iron stores (serum ferritin) decrease but serum iron, TIBC, and red cell morphology are normal
B) iron stores depleted—serum iron decreases, TIBC increases, marrow iron stores absent, TSAT at 15-20%
C) first appearance of microcytic cells, TSAT <10-15%
A) Negative iron balance
B) iron deficiency erythropoiesis
C) Iron deficiency anemia
*absent marrow store: Ferritin <15 ug/L
A man with elevated hemoglobin has increased RBC mass and elevated EPO. Arterial oxygen saturation is normal. He is a non-smoker. What is the next diagnostic step?
A. Measure carboxyhemoglobin
B. Measure hemoglobin oxygen affinity
C. JAK2 mutation testing
D. Bone marrow biopsy
B. Measure hemoglobin oxygen affinity

Microcytic anemia
A) Iron and TSAT increased, RDW normal, target cells
B) Iron, TSAT and TIBC low, ferritin normal/high
C) iron, TSAT and ferritin low, TIBC high
A) Thalassemia
B) Anemia of inflammation
C) Iron deficiency
Orally bioavailable EPO mimetics that act to increase the biological half-life of active hypoxia-inducible factor (HIF
roxadustat
Goal pretransfusion hemoglobin in thalassemia
Hgb 9-10.5 g/dl with oral iron chelators (deferasirox and deferiprone, and IV deferoxamine)
approved for treatment of transfusion-dependent thalassemia; works by binding transforming growth factor B superfamily ligands and reducing Smad2/3 signaling
Luspatercept
Folic acid dose in pregnancy
W/out history of NTD
Prev history of NTD
W/o: 400 ug daily
W/ hx: 5mg daily
What is the only acquired intracorpuscular hemolytic anemia?
PNH
What is the only inherited extracorpuscular hemolytic anemia?
Familial (atypical) HUS
Which feature is NOT common to most patients with hemolytic disorder?
a. Increased MCV, MCH
b. Increased reticulocytes
c. Increased LDH
d. Increased haptoglobin
d. Increased haptoglobin → DECREASED haptoglobin

the essential pathophysiologic process common to all HAs
Increased red cell turnover
- gold standard for proving that the life span of red cells is reduced—red cell survival study